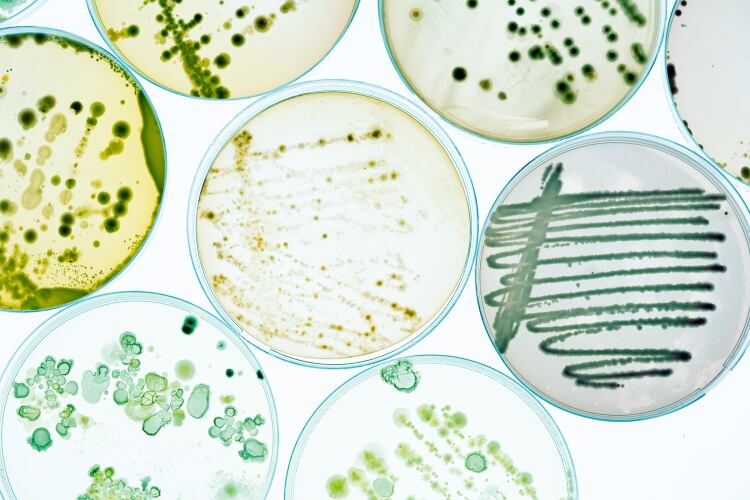

Food and agricultural commodities are among the most traded products in the world. As markets become increasingly globalized and the population continues to expand, the global food supply chain will continue to increase in scale and complexity. Food safety is vital for mass production and distribution models.
It is also a topic that is top-of-mind for many of us. A recent study from the Mars Global Food Safety Center (GFSC) that surveyed more than 1,750 people in the US, UK and China, found 52% of respondents feel food safety is a top-three global issue – and 77% think it’s a top 10 global issue.
The COVID-19 pandemic has had a seismic impact on attitudes to food safety and confidence in food security, Mars GFSC found, with 73% of people predicting COVID-19 will impact the viability of the global supply chain and 71% suggesting COVID will have consequences for the availability of food.
“COVID-19, has put a strain on global and local supply chains and resulted in unprecedented need for collaboration and partnership to act urgently to address supply chain issues, to protect food systems and ultimately, protect those who are most vulnerable,” Director of the China-based GFSC, Dr Guangtao Zhang, explained.
Restrictions on travel have created a ‘tension between supply and demand’ – making the food sector an appealing target for fraudsters, Dr Zhang continued. “We’re seeing economically motivated adulteration, particularly in olive oil and honey as an example.”
It isn’t just COVID that is increasing food safety risks, the food safety expert told this publication.

“New food safety threats are constantly emerging through factors such as global warming, increased globalization of trade and changes in agricultural practices and food production. Based on our experience and our consultation with global experts around the world, these areas represent some of the most critical food safety challenges.”
The nature and scale of food safety challenges are constantly evolving. Understanding this process and developing appropriate safety strategies in response is an important objective for Mars as a company – and the food sector as a whole.
“Climate change exacerbates food safety challenges. If we look back at lengthening supply chains and their inherent complexity, climate change is causing additional shift changes… These threats are inextricably linked to food security and together they negatively affect the resilience of food systems, ultimately impacting the most vulnerable, particularly although not exclusively, in emerging markets.”
Collaboration for a safer food system
Mars opened the GFSC, which is located north of Beijing, in 2015. The centre is a ‘first-of-its-kind’ facility that aims to raise global food safety standards through collaboration.
“We believe that industry has a key role to play in helping identify solutions and sharing knowledge to address the long term food safety challenges impacting the global food supply chain. But the fact is, no single organisation can do this alone – collaboration is critical. That’s why we opened the Mars GFSC and why we’re focused on research, training and collaboration to help make that a reality. We’re on a journey and as always there’s much more to do, but if we can make a difference and move the needle even slightly then that’s a great start to building a better world for tomorrow,” Dr Zhang, who became director of the GFSC in January 2021, explained. “Everyone has the right to safe food and as a global manufacturer we have a responsibility to help solve critical global food safety challenges."
With an emphasis on pre-competitive research, the Mars GFSC leverages insights and expertise from more than 60 partnerships dedicated to ‘innovative, sustainable and responsible’ food safety practices. The World Food Programme (WFP), the Global Alliance for Improved Nutrition (GAIN), Partnership for Aflatoxin Control in Africa (PACA), and the IBM/Mars Consortium for Sequencing the Food Supply Chain are among the organisations that have partnered with Mars since the US$15m facility opened its doors almost six years ago.
“For over 100 years, our company has dedicated itself to ensuring the highest quality in all the work we do. Quality is the uncompromising standard for our actions, and it flows from our passion and our pride in being part of the Mars community. Quality work is the first ingredient of quality brands and the source of our reputation for high standards. However, for us, it’s not just about quality, it is also about taking a responsible and mutual approach. We have a long history at Mars of developing long-term meaningful relationships with our suppliers. This multipronged approach helps us also to remain vigilant when it comes to identifying and mitigating food fraud [and other safety risks].”

Mycotoxin management
The GFSC is prioritising ‘ambitious targets’ in three areas of food safety: mycotoxin risk management, microbial risk management and food integrity, including areas such as food fraud.
These are issues that are close to the majority of consumers’ hearts, Mars’ research suggests. The survey found 60% of respondents expressed concern about keeping food safe from toxins and bacteria, while 58% reported concern over food fraud.
For mycotoxin risk management, the group is developing ‘novel partnerships and breakthrough management strategies’ to tackle mycotoxin contamination, starting with aflatoxins because of the ‘serious health threat they pose, particularly in the developing world’, we were told.
Each year around 4.5bn people are exposed to aflatoxins, which affect around 25% of the world crop area according to FAO estimates. Most human exposure comes from eating contaminated maize, grains and derived products. Mycotoxin consumption has been linked to chronic illnesses, including liver cancer, nephropathy and immune and neurological disorders.
Conventional methods of aflatoxin prevention and removal use of fungicides, and conventional testing and removal of highly contaminated batches have provided ‘valuable reductions in the level of mycotoxins’ over the years, Dr Zhang observed. However, current approaches are yet to achieve total prevention and removal of these molecules. “For us, as a business with consumers’ safety front of mind and a focus on creating a better world tomorrow, we have no choice but to try to help find solutions to aflatoxins.”
Mars’ GFSC is developing capabilities to mitigate mycotoxin challenges across the global food supply chain. “Our tools and analytical methods help support both aflatoxin control and decontamination after-the-fact… The development of novel decontamination strategies will become increasingly critical for the protection of both human and animal health,” Dr Zhang believes.
This could offer an important win in the transition to a more resource-efficient food system, he continued. “The most opportunity for growth is the decontamination of foodstuffs to a level at which it could be repurposed. Food waste due to mycotoxin contamination is a significant contribution to food insecurity in developing nations so if we could find a method to decontaminate the mycotoxin from the foodstuffs to safe levels we could repurpose it for animal feed, increasing overall yield.”
Microbial risks mitigation
Mars’ second food safety focus area at the centre is the development of faster detection, identification and, ultimately, a predictive approach to microbial contamination risks.
“We're looking into a portable hand-held device to look at microbial risk. Genome sequencing capability is pretty difficult to apply in the field/onsite. Soon, you'll be able to bring this solution to the farm, factory, and incident and have it upload to the cloud, analyse and report,” Dr Zhang forecast.
Predictive capabilities are somewhat further down the pipeline. However, Dr Zhang is optimistic about their ability to ‘revolutionise’ food safety by predicting and preventing outbreaks before they occur.
“It's about environment monitoring of food microbiomes, which can revolutionise food safety testing by revealing characteristics about the microbial communities that more traditional methods cannot. Today, typical methods target one or a few genes to test for microbes present in food, requiring prior knowledge of some part of the microbes present. However, methods that provide a non-targeted approach are increasingly desirable to identify other microbial members present and reduce the bias of targeted methods. Doing so could allow us to observe and build a correlation between, say, the changes in a microbiome or given environment and predict and prevent outbreaks before they happen say, a Salmonella/listeria incident, so we can then intervene. With that, food manufacturers could reduce impact and cost, and, crucially, protect consumers,” he enthused.
Food integrity and fraud
The final focus area for GFSC is food integrity. According to the international food safety expert, food fraud is an ‘area of growing concern’ for all parties within the global supply chain.
“As a global company, we’re looking at alternative solutions and methodologies for food authentication. We want to make it more difficult for criminal adulteration to occur because, first and foremost, it’s about protecting the consumer... Addressing it requires a focus on technology, regulation and enforcement, delivering transparency, verifying sourcing, and ultimately ensure that customers and consumers are purchasing and consuming safe food,” Dr Zhang explained.

Mars and its research partners are looking at new technology-enabled mythologies to outwit criminals looking to cash in on food fraud opportunities. For example, Dr Zhang elaborated, the GFSC is using a non-targeted method to look at specific markers or traits to discover ‘multiple characterisations’ of a sample. “What that creates is a situation where it’s more challenging for criminals to adulterate a product because they won’t know the specific elements being assessed.”
This approach is evident in the work GFSC has undertaken on rice authentication alongside the Rice Consortium, Institute for Global Food Security at Queen’s University Belfast (QUB) and Agilent Technologies. Researchers developed a two-tiered approach to monitor and mitigate food fraud in rice. “In this two-year study, the consortium established multiple methods to distinguish authentic rice from adulterated rice, including rapid screening methods and more sophisticated laboratory-based methods. The methods are based on the analysis of multiple variables that create a unique fingerprint of the rice which is difficult to replicate. More work is needed but the study's success could open the door to the same methodologies being used with a wide range of commodities vulnerable to fraud,” according to Dr Zhang.
R&D for the future of food safety: 'We continue to push the envelope'
“It’s very important we continue to push the envelope with ongoing R&D in the field of food safety… We have the freedom - and as we see it the responsibility– at the Mars GFSC to continue to look to the long term, developing new insights and collaborations to help address these areas and raise the bar for all in food safety.
“Our goal is to move to a preventative and predictive space, developing scientific capabilities that help prevent contamination of food by microbes, mycotoxins, or adulterants, and enable robust global supply chains as well," Dr Zhang noted.
Developing digital capabilities and advances in genomics are facilitators for strengthening global food safety capabilities and attaining this vision for the future, Dr Zhang believes. “We are working on taking food safety to a new level by applying genomics and big data to generate new insights and understanding of the total supply chain, enabling controls and standards to be evolved and applied in new ways.”
Research has included a recent paper published on ‘shotgun sequencing’ (a method used for sequencing DNA strands, so-called because of the rapidly expanding, quasi-random firing pattern) and its potential for food authentication and detection of contaminants. “The team developed a pipeline known as ‘FASER’ (Food Authentication from Sequencing Reads) based on high throughput, genomic sequencing data which will provide us with a sensitive, accurate, and novel way to determine the composition of food components and raw materials,” Dr Zhang reflected.
“As we look into the future, digital solutions will have a lot of space to play. There are more handheld devices with digital data solutions on the cloud. The real breakthrough lies in harnessing all that data, identifying links and patterns to predict and prevent.”




